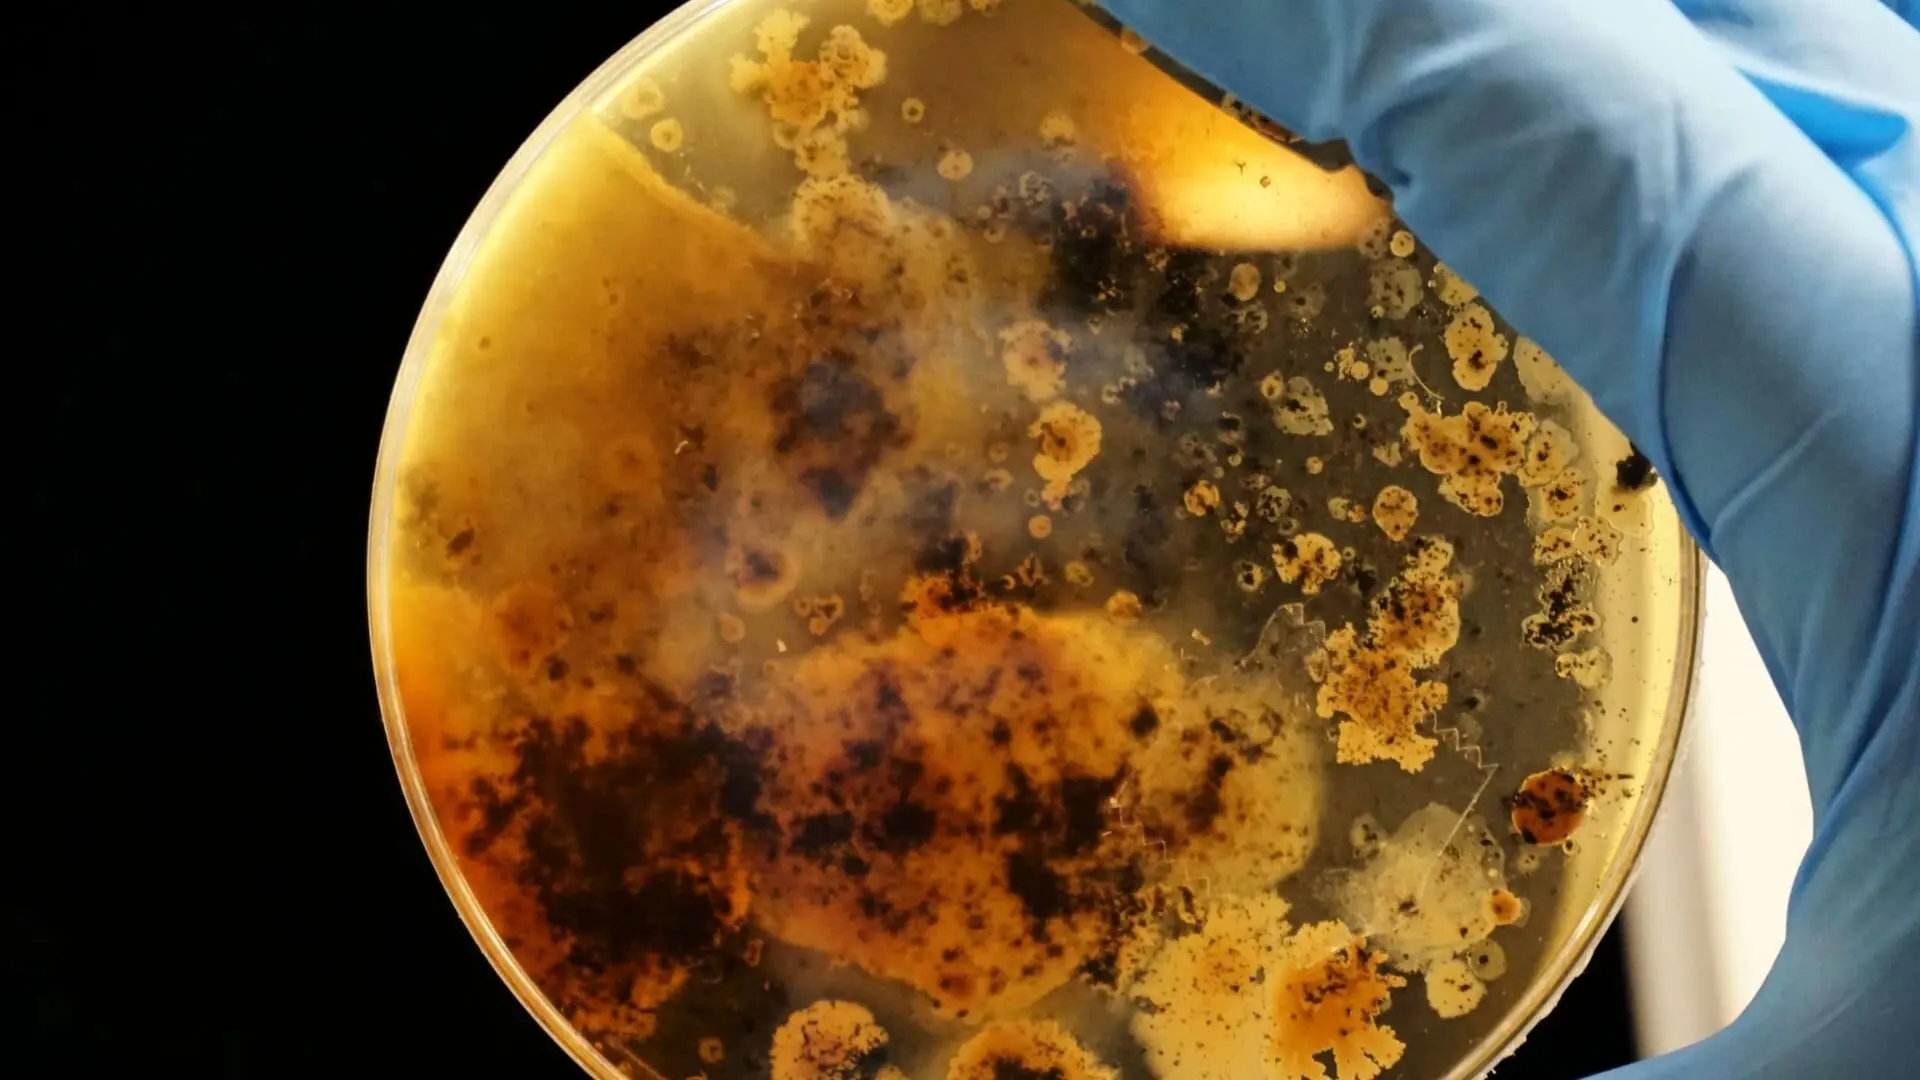
Petrie Dish Rusted Water Bacteria

Locating burst pipes in your home can be more challenging than it may seem.
A large water leak is often the first clue, but it’s not always visible if the problem lurks underground or inside a wall. Sadly, many people only realise this too late and end up facing hefty repair costs for the damage the burst pipe has caused.
However, by being a bit more careful, you can figure out whenever there’s a burst pipe to fix the issue while there is still time to repair it. From hearing dripping sounds to noticing standing water - identifying the plumbing problem early can save you from costly further damage and repairs. So, to make detecting a burst pipe easier, we’ve highlighted seven tell-tale signs often pointing to its presence.
So, let’s check them out!

7 Signs You May Have A Burst Pipe
1. Fluctuating Water Pressure
One of the first signs that point towards the probability of a burst pipe in your home is fluctuations in water pressure. At times, your faucet may fail to provide water; at other times, it might shoot out water at extremely high pressure. However, in most instances of significant damage, the water pressure turns into a dribble.
2. Discoloured And Smelly Water
If your taps are giving off smelly, brown water that reeks of rotten eggs, it could be a burst pipe. This is common in older homes with metal pipes, which can rust when they crack. The water picks up rust and looks dirty. Burst pipes can let in dirt, bacteria, and other nasties, causing unpleasant odours.
In some cases, water flowing through a busted water pipe can pose a health risk as it can get contaminated by hydrogen sulphide, a substance in leaking sewage. You can detect its presence by the smell of rotten eggs in the water.
3. Clanging Or Dripping Noises Coming From The Walls
If you suddenly hear a clanging or dripping noise inside the walls, it can signify a burst pipe. The fluctuating water pressure inside the pipes usually causes these odd and mysterious sounds.
Others might hear a whistling noise as water squeezes through tight spots in damaged pipes. To check if this is happening, turn off all your taps and listen for clanging, dripping, or whistling sounds. Known as a water hammer, this loud noise points to high water pressure and might burst your pipes.
4. Presence Of Mould
Have you recently noticed mould in parts of your home? It may be a vital sign of leaking water from a burst pipe. The mould or mildew growth is most evident on the walls and ceilings when leaking pipes cause it.
If you live in a house with an old plumbing system, try inspecting the area with full pipelines. When you notice large wet spots, large-scale condensation or a prolific mould infestation, it’s a good time to contact a professional plumber. Also, note that spaces with mould often have a musty smell.

5. Water Marks On Walls
If the burst pipe is relatively new, mould can take some time to grow, especially if you have a well-ventilated home. However, you can still figure out the problem by closely observing the walls since water seeps through the walls and creates wet spots that discolour the paint.
Initially, the walls and ceilings of the affected area of your home may look a bit yellowish or brownish. Consult a professional to verify your doubts and avoid major plumbing-related problems in the future.
Note that the parts of your property that have been damaged by water will need renovation to ensure they don’t lead to mould and mildew.
6. Puddles Under Sinks Or Toilets
In some situations, a burst or broken pipe system, such as sinks and toilets, might be more noticeable. Unlike the water pipes inside the walls, these cause immediate damage by flooding your home, especially when there’s a significant leak. If the burst water supply pipe is in the underground system or sewer lines, you might notice wet spots in your yard.
If you run into this problem, switch off the water and electricity at the main source right away, and get in touch with an emergency plumber without delay.
7. Hefty Water Bills
Have you noticed a rise in your water bill? One of the sure-shot signs of something being wrong with the plumbing system is a significant hike in your water bill. If you’re sure about the regular water consumption, tally the recent bill with earlier ones to calculate the discrepancy.
High water bills might be caused by other issues in the plumbing system, like a leaky faucet or toilet. So, contacting a professional plumber will help determine if there’s a burst pipe.
Burst Pipe Signs–Detected!
As you might have guessed, burst pipes can wreak havoc in your home if not handled on time. Additionally, several of the above signs are visible in most households when there’s a burst pipe. So, we recommend contacting a local emergency plumbing service provider as early as possible.
Besides fixing and replacing burst pipes, seasoned plumbers can also alert you about potential causes of the damage. Ensure regular checks on your plumbing system to catch issues early. If you’re in Perth, reach out to the Woolf Plumbing & Gas team. We provide top-notch plumbing services and can swiftly handle your burst or leaking pipes!
Now that you’ve read our blog, you should have a clearer picture of spotting burst pipes, their causes, and ways to fix them. If you’ve got lingering questions or want more details, don’t miss our additional blog resources!




